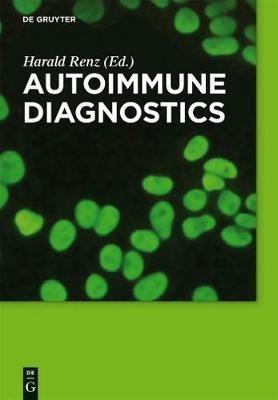

Autoimmune Diagnostics(English, Electronic book text, unknown)
Quick Overview
Product Price Comparison
This book provides a practical and secure guide through the complexity of Autoimmune Diagnostics and Diagnostic Pathways. It contains an overview of significant aspects of Autoimmune Diagnostics, a standard procedure for indirect immunofluorescence and describes all important autoimmune diseases in terms of their diagnostic. In step with actual practice the innovative concept of Diagnostic Pathways leads from symptoms through all steps and branches to diagnosis.